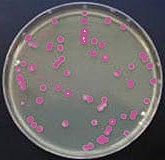
Cornelius Bernardus van Niel - la fotosíntesis depende de la luz

-
El experimento de van Helmont consistió en refutar que los vegetales se alimenten desde el suelo como hasta ese momento se creía. Jan Baptista van Helmont fue un químico, físico, alquimista, médico, y fisiólogo de la región belga de Flandes, quien a principios del siglo XVII realizó uno de los primeros experimentos controlados, que si bien no logró entender la causa del fenómeno descubierto, pudo refutar las teorías vigentes.
(https://es.wikipedia.org/wiki/Jan_Baptista_van_Helmont) -
Joseph Black estudió las propiedades del dióxido de carbono, CO2. Uno de sus experimentos consistió en encerrar un ratón y una vela encendida, dentro de un recipiente con CO2. Dado que la vela se apagó y el ratón murió, llegó a la conclusión de que era un gas irrespirable.
https://es.wikipedia.org/wiki/Joseph_Black#Di%C3%B3xido_de_carbono -
Considerado el descubridor del oxígeno. Fue uno de los primeros en aislarlo en forma gaseosa, y el primero en reconocer su papel fundamental para los organismos vivos.
(https://es.wikipedia.org/wiki/Joseph_Priestley) -
Descubrió la fotosíntesis o producción de oxígeno por las plantas en presencia de luz.
Comprobó que la fotosíntesis permite a la planta utilizar el CO2 para crecer. Observó que las plantas sumergidas en agua emitían pequeñas burbujas y dedujo que era a causa de la luz solar.
Publicó Experiments Upon Vegetables, Discovering Their Great Power of Purifying the Common Air in Sunshine e Injuring It in the Shade and at Night. (https://es.wikipedia.org/wiki/Jan_Ingenhousz) -
Demostró que la fotosíntesis se limita a las partes verdes de la planta y tiene lugar sólo cuando están expuestas a la luz solar, dando por primera vez una visión completa del proceso de fotosíntesis o nutrición vegetal en términos estrictamente químicos.
(https://es.wikipedia.org/wiki/Jean_Senebier) -
Entre los muchos descubrimientos de Lavoisier, los que tuvieron más impacto fueron sus estudios de los procesos vegetales que se relacionaban con los intercambios gaseosos cuando los animales respiran.
(https://es.wikipedia.org/wiki/Antoine_Lavoisier) -
Saussure mostró que el aumento de la masa de la planta a medida que crece, no puede deberse sólo a la captación de CO2, sino también al ingreso de agua. Por lo tanto es la reacción básica por la cual la fotosíntesis se usa para producir alimento (tal como la glucosa).
(https://es.wikipedia.org/wiki/Nicolas-Th%C3%A9odore_de_Saussure) -
La clorofila, biomolécula extremadamente importante en la fotosíntesis, proceso que permite a plantas y algas producir energía a partir de luz solar.
Descubierta por los químicos franceses Pelletier (1788-1842) y Caventou (1795-1877), aislándola de hojas de plantas.
Pelletier introdujo métodos, basados en disolventes suaves, que permiten aislar no solo la clorofila, sino sustancias de importancia farmacológica como la cafeína, la colchicina o la quinina.
(https://es.wikipedia.org/wiki/Clorofila) -
Relacionó la presencia de clorofila con cuerpos subcelulares que se pueden alargar y dividir, así como que la formación de almidón está asociada con la iluminación y que esta sustancia desaparece en oscuridad o cuando los estomas son ocluidos. A Sachs se debe la formulación de la ecuación básica de la fotosíntesis: 6 CO2 + 6 H2O → C6H12O6 + 6 O2
-
Estudiando las bacterias púrpura del azufre y bacterias verdes del azufre fue el primer científico en demostrar que la fotosíntesis es la (fase luminosa) reacción redox dependiente de la luz, en donde el hidrógeno de un compuesto oxidable reduce al dióxido de carbono a material celular. Y se expresa:
2 H2A + CO2 → 2A + CH2O + H2O
(https://es.wikipedia.org/wiki/Cornelius_Bernardus_van_Niel) -
Demostró la fase luminosa, fase clara, fase fotoquímica o reacción de Hill es la primera fase de la fotosíntesis, que depende directamente de la luz o energía lumínica para poder obtener energía química en forma de ATP y NADPH, a partir de la disociación de moléculas de agua, formando oxígeno e hidrólisis biologica. La energía creada en esta fase, será utilizada durante la fase oscura, para de esta forma continuar con la fotosíntesis.
(https://es.wikipedia.org/wiki/Fase_luminosa) -
En la década de 1940, experimenó sobre la fotosíntesis en el alga Chlorella pyrenoidosa, separando compuestos por cromatografía bidimensional e identificándolos por carbono14 y esclareciendo el proceso de asimilación fotoquímica del CO2 por partes verdes de la planta (Ciclo Calvin).
Premio Nobel -Química 1961.
(https://es.wikipedia.org/wiki/Melvin_Calvin)
(De Lanzi (traducido al español por Alejandro Porto) - File:Calvinzyklus.svg, CC0, https://commons.wikimedia.org/w/index.php?curid=25099626) -
sus colegas y él utilizaron componentes de las hojas de las espinacas para realizar la fotosíntesis en ausencia total de células. Ese experimento ayudó a explicar cómo las células de las plantas asimilan el dióxido de carbono, un componente necesario en la fotosíntesis, y cómo forman adenosín trifosfato (ATP), una molécula que actúa como transportador de energía.
(https://es.wikipedia.org/wiki/Daniel_Arnon) -
Lograron identificar la estructura completa del centro de reacción fotosintética, compuesto por cuatro subunidades de proteínas y de 10000 átomos. Por medio de esta estructura, tuvieron la oportunidad de ver con detalle del proceso de la fotosíntesis, siendo la primera vez que se concretó la estructura tridimensional de dicha proteína.
(https://es.wikipedia.org/wiki/Fotos%C3%ADntesis#Siglo_XX) -
En el desarrollo de la presente línea de tiempo se utilizaron las siguientes referencias: (https://es.wikipedia.org/wiki/Fotos%C3%ADntesis#Desde_la_Antigua_Grecia_hasta_el_siglo_XIX) (https://es.wikipedia.org/wiki/Fotos%C3%ADntesis#Siglo_XX) (https://drive.google.com/file/d/1j0wVuZk0x1lMg0D-McigY4cgl2OBMWEq/view?usp=sharing)
A list shows items. A timeline shows sequence.
Use Timetoast to make dates, milestones, and turning points easier to understand in a clear visual format. Timetoast is a timeline maker for work, school, research, and stories.